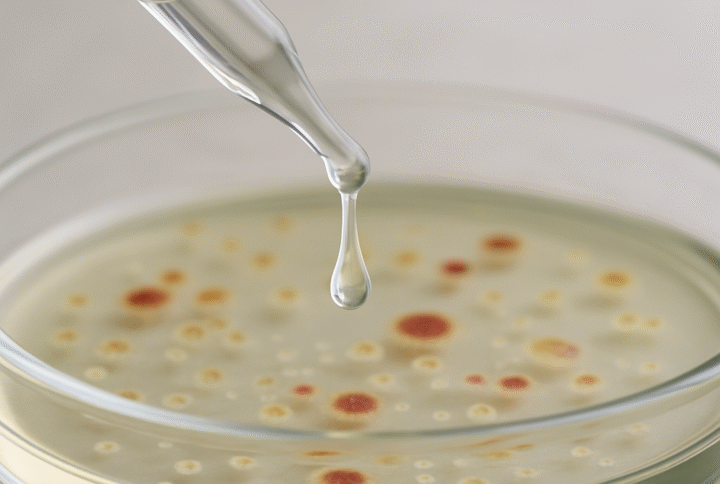

Sodium benzoate is a water-soluble preservative precursor suitable for multiple applications and can be used on its own, especially in the food industry. Its antimicrobial activity is attributed solely to benzoic acid, which forms only under sufficiently acidic conditions. As a result, it is ineffective at pH levels above 6. More detailed information can be found here. It is important to note that sodium benzoate, in its acid form, does not eliminate existing bacteria or fungi but inhibits their growth and reproduction. The conversion factor from sodium benzoate to benzoic acid is approximately 0.847 at pH 2, under conditions of complete protonation; for example, 0.5% sodium benzoate is equivalent to approximately 0.42% benzoic acid.
Sodium benzoate can be added at higher pH levels and then acidified to activate its preservative function. It is commonly used in combination with other preservatives to enhance broad-spectrum protection against bacteria, yeasts, and molds. A blend of sodium benzoate and potassium sorbate (in a ratio 2:1) in water is well known for its strong efficacy against yeasts and molds, while exhibiting only mild antibacterial activity. To further enhance its effectiveness against both Gram-positive and Gram-negative bacteria, the addition of phenoxyethanol or benzyl alcohol is recommended.
Sodium benzoate is used not only as a preservative precursor in personal care products but also in food, as it does not accumulate in the body. It meets the requirements for preserving natural certified cosmetics and is often included in blends to protect natural plant extracts.